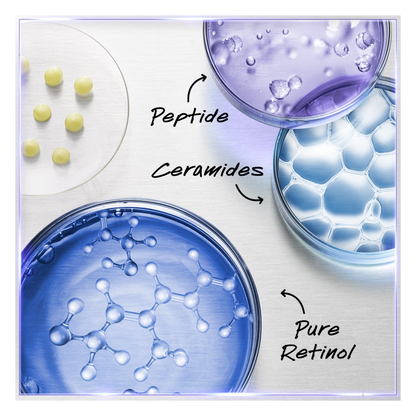
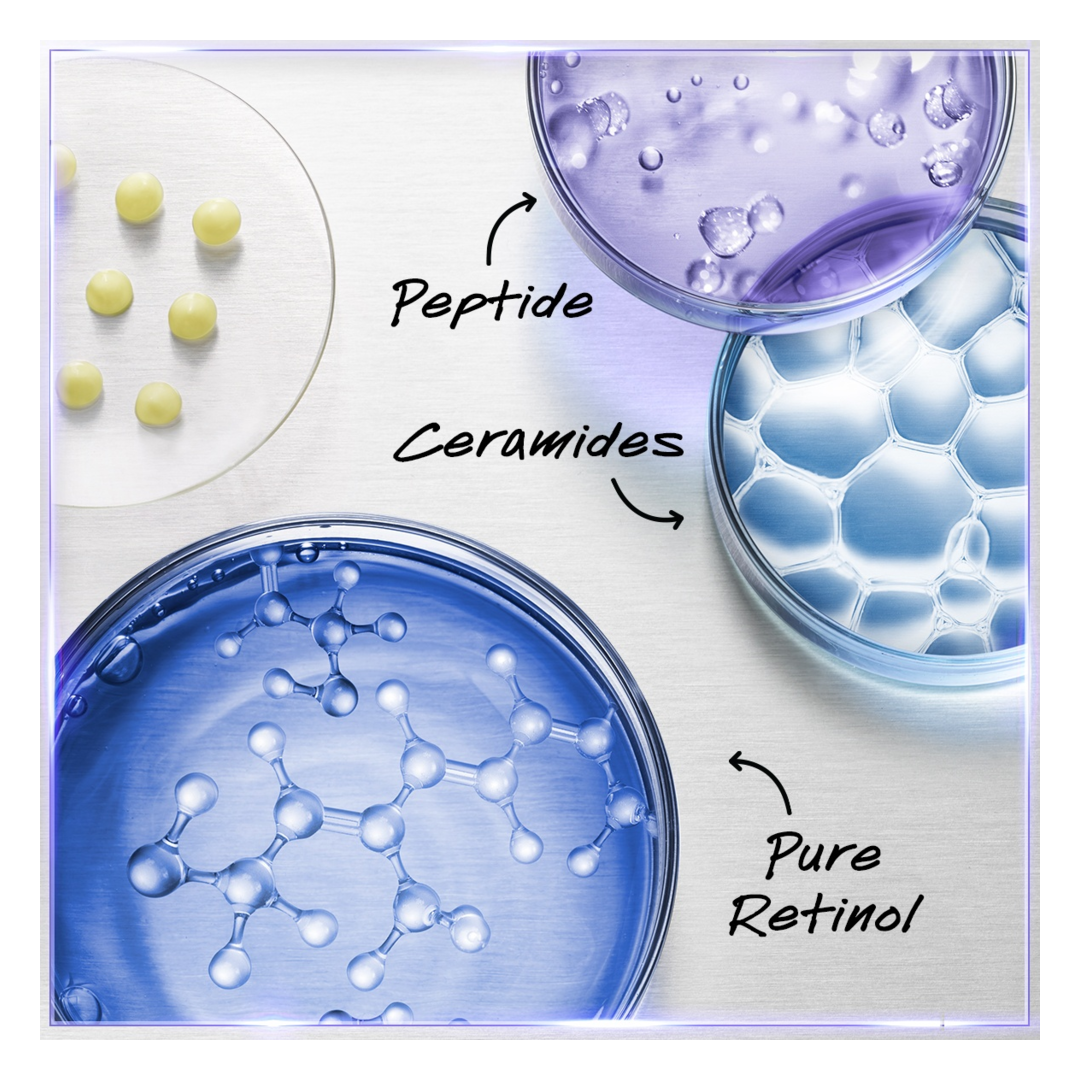

PRODUCT DESCRIPTION
'˜'Tackle fine lines, wrinkles and skin texture with the Kiehl's Retinol Skin-Renewing Daily Micro-Dose Serum, a gentle anti-ageing treatment that visibly renews your skin.'' - Darcey, Escentual Beauty Team.
Why you'll love Kiehl's Retinol Daily Micro-Dose Serum:
- Firming and smoothing anti-ageing serum suitable for all skin types.
- 93% of beauty lovers found their skin's texture was more refined.
- 85% of users agreed that their skin looked years younger.
- Centres around a powerful trio of ingredients that increase cell turnover and strengthen the skin barrier.
- Suitable for sensitive skin and first-time retinol users.
- Features a daily-strength dose of pure retinol.
What You Need To Know:
Designed to refine your skin for a more youthful-looking complexion, the Kiehl's Micro-Dose Serum is an anti-ageing treatment enriched with a potent dose of pure retinol - in fact, it features a daily-dose of the purest form of retinol available over-the-counter. This show-stopping active accelerates skin cell turnover to bring younger and radiant skin to the surface as the formula smooths away fine lines and wrinkles. Ceramides work to strengthen the skin barrier and enhance sensitive skin's tolerance to retinol, while the addition of peptides supports optimal youth-renewing results. Oh, and the serum does all this without causing major signs of redness, dryness or peeling.
Why it's Escentual:
Here at Escentual, we love multi-functional skincare - and this Kiehl's Retinol anti-ageing serum is just that! It harnesses the refining and skin-smoothing benefits of retinol, while still being suitable for even the most sensitive skin. But don't just take our word for it - 90% of beauty lovers agreed that their skin felt comfortable after application, making it perfect for first-time retinol users.
Kiehl's fans will love the luxurious deep purple glass bottle - and we think that everyone will appreciate the fact that the anti-wrinkle serum comes with a handy pump dispenser for non-messy and fuss-free application. Plus, a little goes a long way as the soft and non-sticky texture easily glides across your skin, so you can enjoy supple and youthful skin for longer.
The Best Way To Use It:
Use at night-time. After cleansing, apply the Retinol Skin-Renewing Daily Micro-Dose Serum to the entire face and the neck if needed. You can apply it to the under-eye area, but take care to avoid contact with the eyes and the eyelid area.
Always use SPF the following day as retinol increases the skin's sensitivity to sunlight.
Values:
Dermatologist tested.
Ingredients
Ingredients
Aqua / Water, Glycerin, Butylene Glycol, Pentylene Glycol, Niacinamide, Cetyl Alcohol, Isohexadecane, Isononyl Isononanoate, Diisopropyl Sebacate, 2-Oleamido-1, 3-Octadecanediol, 4-T-Butylcyclohexanol, Acetyl Dipeptide-1 Cetyl Ester, Adenosine, Ceramide Np, Hydroxypalmitoyl Sphinganine, Lauroyl Lysine, Octyldodecanol, Pentaerythrityl Tetra-Di-T-Butyl Hydroxyhydrocinnamate, Sodium Chloride, Sodium Hyaluronate, Sodium Hydroxide, Trisodium Ethylenediamine Disuccinate, Retinol, Tocopherol, Dicaprylyl Ether, Ammonium Polyacryloyldimethyl Taurate, Behenyl Alcohol, Caprylyl Glycol, Carbomer, Cetearyl Alcohol, Cetearyl Glucoside, Glycine Soja Oil / Soybean Oil, Helianthus Annuus Seed Oil / Sunflower Seed Oil, Hydroxyethylcellulose, Lecithin, Phenethyl Alcohol, Poloxamer 188, Polycaprolactone, Sorbitan Laurate, Steareth-100, Ci 40800 / Beta-Carotene, Chlorphenesin, Phenoxyethanol.
Delivery
Delivery
Next Day Delivery Pass - £9.95
FREE Next Day Delivery on orders over £20 (after discounts) for a whole year! (UK mainland only).
Standard Delivery - £2.45
FREE if your order is over £30! Delivered in 3-5 working days.
2 Day Delivery - £3.50
Delivered in 2 working days (order before 10 PM UK time).
Next Day Delivery - £5.95
Delivered in 1 working day (order before 4 PM UK time).
DPD Local Pickup (Next Day) - £4.95
Pick up next working day (order before 4 PM UK time).
Question about delivery? Chat with us! Full delivery terms & conditions here.
Escentual Points
Escentual Points
Earn and Spend Escentual Points
For every £1 you spend with us, you’ll earn 2 Escentual Points—making it easy to build up rewards with each purchase! Each point is worth 1p, so the savings quickly add up.
For example, spend £50 and you’ll earn 100 Escentual Points to use on future purchases!